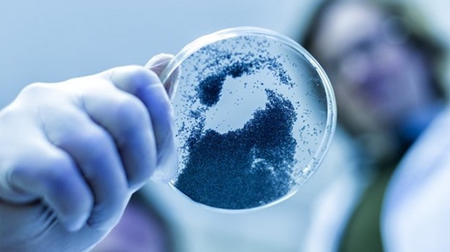

来源:材料科技在线|
发表时间:2018-07-16
点击:13956
多年来,科学家们一直认为硅是锂离子电池领域的一种极具前景的材料。最主要的原因是,使用它作为电池阳极可能意味着电池的容量会是当前版本的10倍——至少在理论上是这样。但在现实中,当电池的使用时长超过充电周期时,它很容易破裂。现在,挪威能源技术研究所的科学家们声称他们已经用一种称为硅x的新材料克服了这个问题。
研究人员将这种新材料描述为他们一直在寻找的“x因素”,找到这种新材料并不简单。多年来,世界各地的科学家一直在努力研究如何将相对脆弱的硅作为电池阳极,也就是电流流入电池的那一极。
我们已经看到许多实验技术在实验室中显示出了巨大的应用潜力。一些更有趣的方法包括将硅置于一个石墨烯笼中,将其压成粉末,将其作为长度为几微米的纳米线,或者将其部署成纳米粒子的形式。
使用普通硅作为阳极的问题在于,当电池充电时,这些颗粒会膨胀多达400%,然后在放电时恢复正常,从而导致电池破裂。美国能源技术研究所的科学家们说,他们已经用一种新型硅合金克服了这个问题,这种合金是由硅纳米颗粒和一种不知名的材料精心混合而成,目前正在进行这项技术的专利申请。
该团队已在实验室进行测试并表示,尽管新电池的最初设计会考虑容量,但其在整个充电周期内的稳定性意味着它的容量将远远高于快速降解的纯硅阳极电池,并且其容量比现在使用的石墨阳极电池的充电容量高出三到五倍。
“本文由新材料在线®平台入驻媒体号材料科技在线提供,观点仅代表作者本人,不代表本网站及新材料在线®立场,本站不对文章内容真实性、准确性等负责,尤其不对文中产品有关功能性、效果等提供担保。本站提醒读者,文章仅供学习参考,不构成任何投资及应用建议。如需转载,请联系原作者。如涉及作品内容、版权和其它问题,请与我们联系,我们将在第一时间处理!本站拥有对此声明的最终解释权。”

